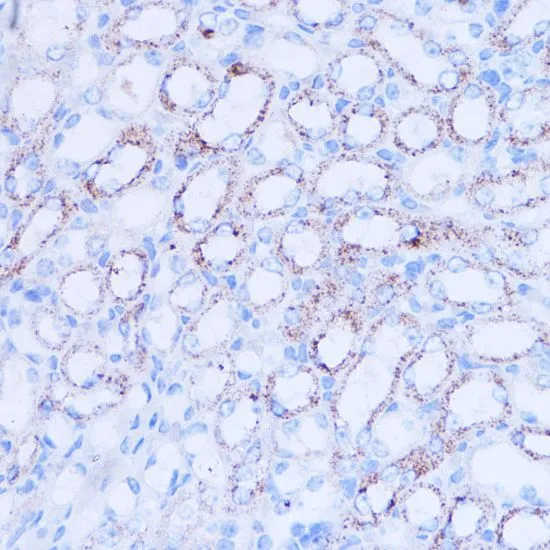

WB analysis of 293T cell lysate using GTX33499 SIRT3 antibody. Dilution : 1:1000 Loading : 25microg per lane
SIRT3 antibody
GTX33499
ApplicationsImmunoFluorescence, Western Blot, ImmunoCytoChemistry, ImmunoHistoChemistry, ImmunoHistoChemistry Paraffin
Product group Antibodies
TargetSIRT3
Overview
- SupplierGeneTex
- Product NameSIRT3 antibody - KO/KD Validated
- Delivery Days Customer9
- Application Supplier NoteWB: 1:500 - 1:1000. ICC/IF: 1:50 - 1:100. IHC-P: 1:20 - 1:50. *Optimal dilutions/concentrations should be determined by the researcher.Not tested in other applications.
- ApplicationsImmunoFluorescence, Western Blot, ImmunoCytoChemistry, ImmunoHistoChemistry, ImmunoHistoChemistry Paraffin
- CertificationResearch Use Only
- ClonalityPolyclonal
- ConjugateUnconjugated
- Gene ID23410
- Target nameSIRT3
- Target descriptionsirtuin 3
- Target synonymsmitochondrial nicotinamide adenine dinucleotide-dependent deacetylase; NAD-dependent deacetylase sirtuin-3, mitochondrial; NAD-dependent protein deacetylase sirtuin-3, mitochondrial; regulatory protein SIR2 homolog 3; silent mating type information regulation 2, S.cerevisiae, homolog 3; SIR2L3; sir2-like 3; SIR2-like protein 3; sirtuin type 3
- HostRabbit
- IsotypeIgG
- Protein IDQ9NTG7
- Protein NameNAD-dependent protein deacetylase sirtuin-3, mitochondrial
- Scientific DescriptionThis gene encodes a member of the sirtuin family of proteins, homologs to the yeast Sir2 protein. Members of the sirtuin family are characterized by a sirtuin core domain and grouped into four classes. The functions of human sirtuins have not yet been determined; however, yeast sirtuin proteins are known to regulate epigenetic gene silencing and suppress recombination of rDNA. Studies suggest that the human sirtuins may function as intracellular regulatory proteins with mono-ADP-ribosyltransferase activity. The protein encoded by this gene is included in class I of the sirtuin family. Two alternatively spliced transcript variants that encode different proteins have been described for this gene. [provided by RefSeq, Jul 2008]
- Storage Instruction-20°C or -80°C,2°C to 8°C
- UNSPSC12352203
References
- Kidney dysfunction induced by a sucrose-rich diet in rat involves mitochondria ROS generation, cardiolipin changes, and the decline of autophagy protein markers. Ruiz-Ramirez A et al., 2020 Jan 1, Am J Physiol Renal PhysiolRead more